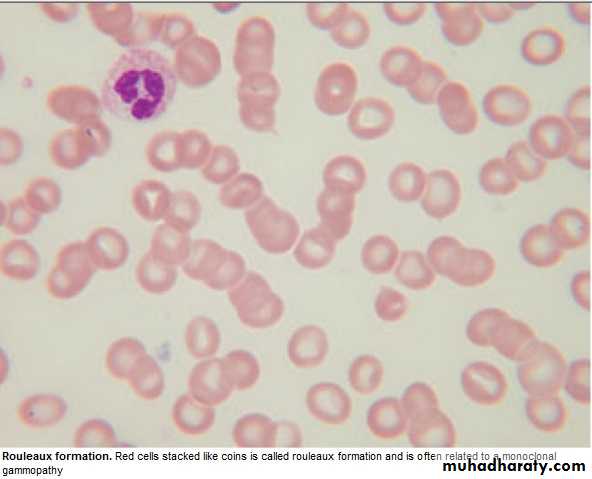

Haematology
Dr Khudhair Abass AliCollege of Medicine – Baghdad University
Objectives:
Multiple Myeloma.Myeloproliferative diseases:
Myelofibrosis.
Essential Thrombocythemia.
PRV\
Infectious mononucleosis.
Multiple Myeloma (MM) Lecture 9
* Malignant prolif. Of plasma cells.Normally: Plasma cell produce polyclonal Ig = variety of heavy chains are produced,
& each may be of kappa or lambda light chain type.
Myeloma: Plasma cells produce Ig of a single heavy & light chain (monoclonal prot-
ein = paraprotein), in some cases only light chain is produced →appear
in urine (Bence Jones proteinuria).
Classification:
Type of paraprotein %
IgG 55
IgA 21
Light chain only 22
Others(D,E, non-secretory) 2
*Majority of malignant plasma cells are present in BM ,small No. in circulation.
*Malignant plasma cells produce cytokines → stimulate osteoclast →bone reabso-
rption. → lytic lesions → pain, fracture, & ↑ Ca++.
*BM involv. → An. or pancytopenia.
Clinically:
4/100 000/y, M:F 2:I,Median age 60-70y.PATHOLOGY EFFECTS SYMPTOMS
Marrow involv. Bone erosion by osteoclast Pain
path. Fracture Severe local pain
↑Ca++ Lethargy,thirst.
BM failure → An. Tiredness
↑ paraprot.& L chain Renal damage Renal failure
↑ viscocity Blurred vission, headach
Amyloidosis Nephrotic syndrome
↓ Normal plasma cells ↓ immunity ↑ infection(UTI,Resp.)
Diagnosis: Requires 2 of the followings:
1. BM malignant plasma cells >20% (BM aspiration)
2. S & or urinary paraprotein.(Bl & urine protein electrophoresis)
3. Skeletal lytic lesions.(X-rays/skeletal survey)
other investigations:
1. FBC: (Degree of BM failure),↑ ESR (not specific), urea & electrolytes, creatinine, uric ac., S.Ca++ & albumin.
coagulaton screen?, B2 microglobulin, MRI( SC compr.).
2.Bl. & urine immunoelectrophoresis(type of paraprotein).
3.Quantification of paraprotein,& other Igs( ↓ = immune paresis).
Management:
Asymptomatic: treat. may not be required.Immediate support:
1. High fluid intake to treat renal impairment & hyper Ca++.
2. Analgesia for bone pain.
3. Biphosphanates for hyperCa++(it also reduce bone pain & risk of fracture, may cause apoptosis of malignant plasma cells)
4.Allopurinol:prevent urate nephropathy.
5. Plasmapheresis for hyperviscocity.
Chemotherapy:
1. Old pts.: Ist line chemotherapy: Thalidomide + Melphalan + Prednisolone →
median survival 51 Ms. 2. Young Pts.: Ist line chemo. until max. response(plateau phase),then autologous
BMT (prolong survival but no cure).
3. Relapse: Bortezomib.
Radiotherapy:
For localized pain not responding to analgesia, pathological fracture & for emergency treat. Of SC compr. Complicating extradural plasmacytoma.
Prognosis: Poor prognostic features: ↑ B2-microglobulin, ↓ albumin, ↓Hb or ↑Ca++ at presentation. 5% survive 5y.
Myeloproliferative disorders:
Group of diseases characterized by clonal prolif. Of marrow erythroid precursors(PRV),
Megakaryocytes( Essential thrombocythaemia & Myelofibrosis) or myeloid cell CML), some having overlapping features,& often progression from one to another e.g. PRV to myelofibrosis.
MYELOFIBROSIS:
BM is initially hypercellular, with excess abnormal megakaryocytes which release
growth factors e.g. platelet-derived growth factor, to the marrow microenvironment
→ reactive prolif. of fibroblasts →marrow fibrosis.
Clinically: Age ↑ ˃ 50y, Lassitude, wt. loss, night sweat. SPLEEN MASSIVELY ENLARGED (extramedullary haematopoiesis).
Lab.: 1.FBC: Leukoerythroblastic An. ↑ reticulocyte count, tear drop RBC. WBC: ↓ - ↑ .
Platelets: ↑ , N, ↓, Giant form may be seen. 2. ↑uric ac., folate def. is common.
3. BM aspirate: difficult, Biopsy: Excess megakaryocytes,↑ reticulin & fibrous T. replac.
4. JAK -2 mutation 50%.
Management & prognosis:
Median survival: 4y.( range 1-20y).Treat.: Control symptoms:
RBC transf. for An.
Folic ac. To prevent def.
Hydroxycarbamide to control spleen size, WBC count, systemic symptoms.
Splenectomy: grossly enlarged, or pancytopenia(hypersplenism)
BMT: may be considered for young pt.
Essential thrombocythaemia;
Malignant prolif. Of megakaryocytes result in raised level of circulating platelets,that are often dysfunctional.
Reactive causes of ↑plat. must be excluded.
Clinically: Median age: 60y, may be asymptomatic with ↑ plat. Count.
Vascular occlusion or Bleeding.
Small % → Acute leukemia or Myelofibrosis.
Lab.: ↑ plat.,JAK-2mutation 50%
Treat.:
* ↓ risk pt.: ( age < 40y, plat.c. < 1000 x 10 9/L & no bleeding or thrombosis) →
may not require treat.
* Plat, c. > 1000 x 10 9/L, with symptoms, or with risk factors for thrombosis(DM,
HTN),→ Treat. to control plat.c../ e.g. Hydroxycarbamide or Anagrelide(inh. Of
megakaryocytes maturation). Radioactive phosphorus( P32) for old age.
* Aspirin for all pts. to reduce risk of thrombosis.
Infectious mononucleosis (IM)
*Acute viral illness, most often caused by EBV(CMV, HIV-1 & Toxoplasmosis may
cause similar clinical syndrome).acquired from asymptomatic excreters via saliva
by droplet infection or kissing.
Clinically: I.P.:Prolonged, undetermined.
Fever, Headache,& malaise,followed by severe pharyngitis (± tonsillar exudate, Ant. & Post. cervical LN-pathy), palatal petechiae, periorbital oedema,splenomegaly, inguinal & axillary LN. & macular, petechial,or erythema multiforme rashes may
occure. Fever resolved in 2 wks & fatigue in another 2 wks.
Death is rare : resp.obst., splenic rupture, thrombocytopenia, or encephalitis.
Investigations: 1. FBC: Atyical Lymphocytes in peripheral Bl.
2. Paul-Bunnel or Monospot test: detect heterophil Ab.present during acute illness
& convalescence (to be repeated if initially –ve).
3.Specific EBV serology (immunofluorescence) can be used to confirm the diagnosis
Complications:
Common Uncommon RareSevere pharyngeal Odema Neurological Ruptured spleen
Antibiotic-induced rash Cranial nerve palsies Resp. obstruction
(80-90% with Ampicillin) Polyneuritis Agranulocytosis
Prolonged post-viral fatigue Transverse myelitis Lymphoprplif. Dis.
Hepatitis(80%) Meningoencephalitis
Jaundice( <10%) Hematological Hemolytic An. Thrombocytopenia Renal Abnormal GUE Interstitial nephritis Cardiac
Myocarditis, abnormal ECG
Pericarditis
Management:
1.Symptomatic:2.If throat culture revealed B-haemolytic streptococci → penicillin.(avoid
ampicillin
& amoxicillin → macular rash .
3.Severe pharyng. Odema → prednisolone 30 mg 5d.
4.Antiviral: not effective.
5.Avoid contact sports (splenic rupture) until splenomegay has completely
resolved .
Summary
MM:IgG is the most common type.
Diagnosis 1. > 20% plasma cells in BM.
2.Serum or Urine paraprotein.
3.Skeletal lytic lesions.
R: Thalidomide + Melphalan+ Prednisolone
Myelofibrosis:
Massive splenomegally.
R: Symptomatic ± Hydroxycarbamide.
Splenectomy, BMT.
ET: ↑plat. clinically: vascular occlusion or bleeding.
R: Aspirin + Hydroxycarbamide when indicated.
Infectious mononucleosis: EBV, Atypical L, Paul-Bunnel,symptom.R.